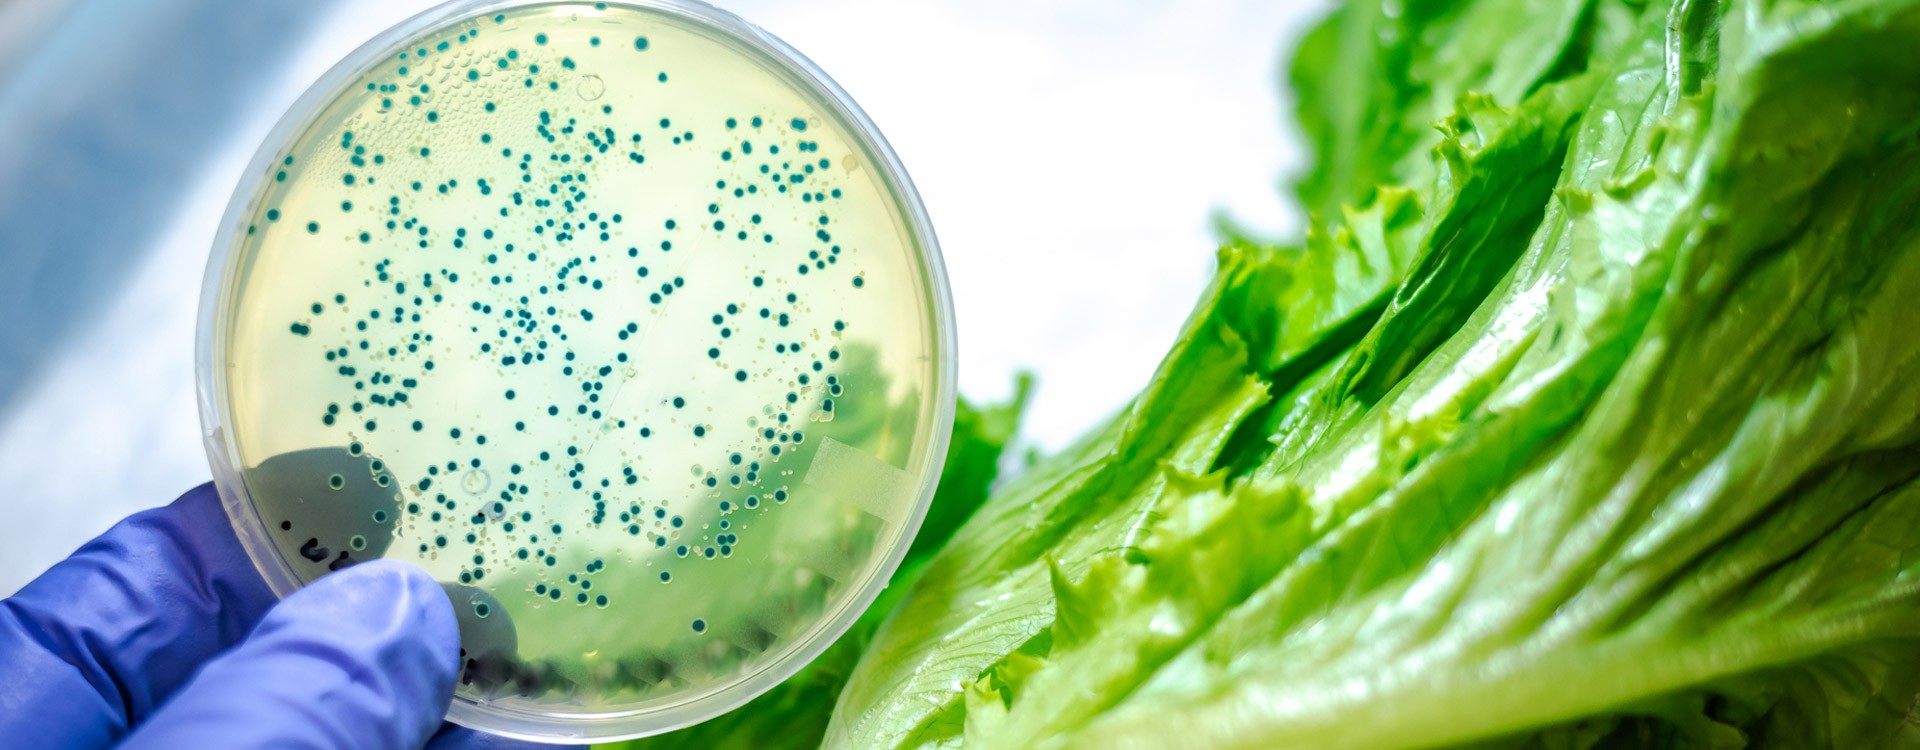
The impact of oregano (origanum heracleoticum) essential oil and carvacrol on virulence gene transcription by escherichia coli O157:H7

Action anticancérigène de l'Huile Essentielle d'Origanum Compactum : application sur la lignée cancéreuse humaine du nasopharynx "Hep"
L'Origan -Origanum compactum- est une plante médicinale couramment utilisée pour certains traitements thérapeutiques notamment des affections gastriques et cutanées; elle montre aussi un intérêt ma...